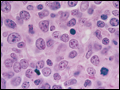

PART 7: Oncology and Hematology
SECTION 2 Hematopoietic Disorders
110 Malignancies of Lymphoid Cells
 | Figure 110-1 Relative frequency of lymphoid malignancies. ALL, acute lymphoid leukemia; CLL, chronic lymphoid leukemia; MALT, mucosa-associated lymphoid tissue. |
view large |
 | Figure 110-2 Pathway of normal B cell differentiation and relationship to B cell lymphomas. HLA-DR, CD10, CD19, CD20, CD21, CD22, CD5, and CD38 are cell markers used to distinguish stages of development. Terminal transferase (TdT) is a cellular enzyme. Immunoglobulin heavy chain gene rearrangement (HCR) and light chain gene rearrangement or... |
view large |
 | Figure 110-3 Pathway of normal T cell differentiation and relationship to T cell lymphomas. CD1, CD2, CD3, CD4, CD5, CD6, CD7, CD8, CD38, and CD71 are cell markers used to distinguish stages of development. T cell antigen receptors (TCR) rearrange in the thymus, and mature T cells emigrate to nodes and peripheral blood. ALL, acute lymphoid... |
view large |
 | Figure 110-4 Relationship of International Prognostic Index (IPI) to survival. Kaplan-Meier survival curves for 1300 patients with various kinds of lymphoma stratified according to the IPI. |
view large |
 | Figure 110-5 Acute lymphoblastic leukemia. The cells are heterogeneous in size, have round or convoluted nuclei, high nuclear/cytoplasmic ratio, and absence of cytoplasmic granules. |
view large |
 | Figure 110-6 Chronic lymphocytic leukemia. The peripheral white blood cell count is high due to increased numbers of small, well–differentiated, normal-appearing lymphocytes. The leukemia lymphocytes are fragile, and substantial numbers of broken, smudged cells are usually also present on the blood smear. |
view large |
 | Figure 110-7 Follicular lymphoma. The normal nodal architecture is effaced by nodular expansions of tumor cells. Nodules vary in size and contain predominantly small lymphocytes with cleaved nuclei along with variable numbers of larger cells with vesicular chromatin and prominent nucleoli. |
view large |
| Figure 110-8 Diffuse large B cell lymphoma. The neoplastic cells are heterogeneous but predominantly large cells with vesicular chromatin and prominent nucleoli. |
view large |
 | Figure 110-9 Burkitt's lymphoma. The neoplastic cells are homogeneous, medium-sized B cells with frequent mitotic figures, a morphologic correlate of high growth fraction. Reactive macrophages are scattered through the tumor and their pale cytoplasm in a background of blue-staining tumor cells give the tumor a so-called starry sky appearance. |
view large |
 | Figure 110-10 Adult T cell leukemia/lymphoma. Peripheral blood smear showing leukemia cells with typical "flower-shaped" nucleus. |
view large |
 | Figure 110-11 Mixed-cellularity Hodgkin's disease. A Reed-Sternberg cell is present near the center of the field; a large cell with a bilobed nucleus and prominent nucleoli giving an "owl's eyes" appearance. The majority of the cells are normal lymphocytes, neutrophils, and eosinophils that form a pleomorphic cellular infiltrate. |
view large |

